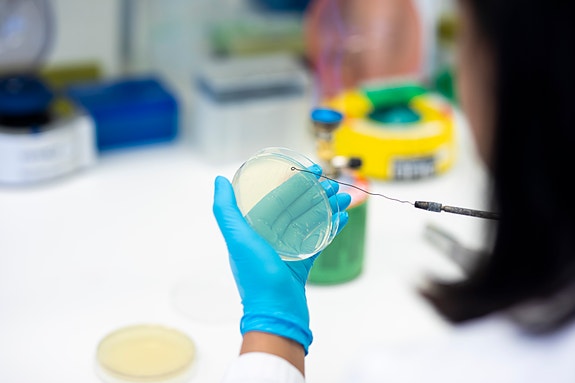
Lars Martin Bøe / Universitetet i Innlandet

Dekan
Universitetet i Innlandet
- Frist 8.3.2026
- Ansettelsesform Engasjement
Vil du lede et fakultet med 700 studenter og 120 ansatte? Vi søker
Vil du lede et fakultet der natur, bærekraft og bioteknologi er en del av hverdagen?
Ved Universitetet i Innlandet (INN) søker vi en strategisk og samlende dekan til Fakultet for anvendt økologi, landbruksfag og bioteknologi (ALB). Stillingen passer for deg som vil bruke tung faglig bakgrunn og solid ledererfaring til å videreutvikle sterke fagmiljøer, utdanninger og forskning tett på natur, næringsliv og samfunnsliv - lokalt, nasjonalt og internasjonalt.
Som dekan har du det overordnede ansvaret for fakultetets samlede virksomhet - faglig, strategisk og operativt. Du leder og utvikler forskning, utdanning og administrativ drift, og har arbeidsgiveransvar for om lag 120 medarbeidere. Du inngår i rektors ledergruppe og får en sentral rolle i å videreutvikle Universitetet i Innlandet som universitet og samfunnsaktør.
Rollen som dekan
Som dekan ved ALB forventes du å videreutvikle fakultetet som en tydelig og anerkjent utdannings- og forskningsaktør innen bioingeniørfag og bioteknologi, jordbruk og skogbruk, utmarksforvaltning og anvendt økologi. Du bygger videre på eksisterende faglig styrke, samtidig som du bidrar til nyskaping, kvalitet og relevans.
Du har ansvar for å lede og utvikle den faglige virksomheten ved fakultetet, sikre høy kvalitet og relevans i utdanning, forskning og eksternfinansiert aktivitet, drive fram kvalitetsutvikling, nødvendig omstilling og digitalisering av undervisnings- og arbeidsformer, og styrke fagmiljøenes kompetanse og kapasitet til beste for studieprogrammene og forskningen. Du bygger og videreutvikler varige relasjoner til arbeids- og samfunnsliv regionalt, nasjonalt og internasjonalt, ivaretar fakultetets ansvar for informasjon og samfunnskontakt og bidrar til synlighet i offentligheten. Du legger til rette for studentdemokrati og sikrer studentenes medvirkning på fakultetsnivå. Du bidrar aktivt til medvirkning og medbestemmelse for ansatte gjennom et godt partssamarbeid, arbeid med likestilling, inkludering og mangfold og et godt lærings- og arbeidsmiljø.
Du leder fakultetets ledergruppe, som består av dekan, prodekaner for utdanning og forskning, administrativ leder, instituttledere og ph.d.-leder. Du leder også fakultetsrådet, som har eksterne representanter og representanter for ansatte og studenter. Arbeidssted Hamar eller Evenstad etter avtale. Stillingen innebærer tilstedeværelse ved alle fakultetets studiesteder, og reisevirksomhet må påregnes.
Hvem er du?
Vi søker en leder som kan lede den videre utviklingen av fakultetet og samarbeide bredt i organisasjonen. Det er viktig at du har engasjement for lærings- og arbeidsmiljø. Vi ser etter deg som har:
Høy vitenskapelig kompetanse på doktorgradsnivå innen ett eller flere av fakultetets fagområder.
Relevant ledererfaring på strategisk nivå.
Erfaring fra ledelse av utdannings- og/eller forskningsvirksomhet.
God skriftlig og muntlig fremstillingsevne på skandinavisk og engelsk er nødvendig.
Det er ønskelig at du har innsikt i internasjonale og nasjonale utviklingstrender innen høyere utdanning og forskning, og erfaring med samfunnskontakt og samarbeid med offentlige aktører og næringsliv, gjerne også internasjonalt.
Vi søker en person som er fremtidsrettet og utviklingsorientert, og som er tydelig og samlende i lederrollen. Du er relasjons- og samarbeidsorientert, og lykkes med å motivere, inkludere og utvikle andre. Du er en trygg kommunikator og relasjonsbygger som trives med å bygge nettverk regionalt, nasjonalt og internasjonalt. Dine personlige egenskaper gjør deg til en leder som skaper tillit og driver utviklingsprosesser framover.
Vurderingen av hvilken kandidat som er best kvalifisert vil være en helhetlig vurdering av kvalifikasjoner slik de er formulert i annonseteksten. Lederkompetanse og personlig egnethet vil tillegges særlig vekt i tillegg til utdanning, motivasjon og øvrige kvalifikasjonskrav slik de er formulert i annonseteksten.
Lederkompetanse vil bli kartlagt gjennom eksternt rekrutteringsbyrå med bruk av intervju og testverktøy.
Stillingen med tilhørende arbeidsoppgaver skal ivaretas i samsvar med gjeldende lov- og regelverk for statsansatte, herunder også Lov om kontroll med eksport av strategiske varer, tjenester og teknologi m.v. Kandidater som etter vurdering av søknad og vedlegg kommer i konflikt med kriteriene i sistnevnte lov, vil ikke kunne tiltre stillingen ved Universitetet i Innlandet. Nødvendige godkjenninger må opprettholdes gjennom hele ansettelsesforholdet.
Om fakultetet
Fakultet for anvendt økologi, landbruksfag og bioteknologi har rundt 700 studenter og 120 ansatte. Forskningen og utdanningene våre er tett knyttet til bærekraftig produksjon, bruk og forvaltning av biologiske ressurser som vilt, fisk, skog, kulturplanter og husdyr, og til produkter og tjenester som springer ut av biologisk materiale og bioteknologiske løsninger, samt samt på ulike menneske- og dyrehelserelaterte temaer gjennom en en-helse tilnærming.
Vi tilbyr utdanninger på bachelor-, master- og ph.d.-nivå og har ansvar for ph.d.-programmet i anvendt økologi og bioteknologi. Internasjonalisering er en viktig del av virksomheten vår, og vi leder blant annet internasjonale nettverk (som IRSAE) for å heve kvaliteten på utdanning og forskning. Mange av problemstillingene vi jobber med er regionale, men vi arbeider i et internasjonalt landskap med samarbeidspartnere verden over.
Fakultetet har aktivitet på studiested Evenstad, Hamar og Blæstad (utenfor Hamar), og nærheten til natur, forvaltning og næringsliv preger både forskningen og studietilbudene våre. Se filmer fra våre studesteder på vår youtube-kanal: https://www.youtube.com/channel/UC4dt2hoM-OvxYHXG_9U7LiQ/featured.
Vi tilbyr
en nøkkelrolle ved et universitet i utvikling med sterke fagmiljø og engasjerte kolleger.
lønn i stilling som dekan etter kompetanse og erfaring.
medlemskap i Statens pensjonskasse, med blant annet gode pensjons- og forsikringsordninger.
gode arbeidsbetingelser.
For mer informasjon om INN som arbeidsgiver, se inn.no.
Søke stillingen
Søknaden leveres elektronisk via "Søk stillingen". Den må inneholde et søknadsbrev, CV med oversikt over utdanning, erfaring og annen relevant kompetanse, samt kopi av vitnemål, attester og andre vedlegg som du mener er viktige.
Har du spørsmål om hvordan du laster opp vedlegg eller tekniske utfordringer, kan du kontakte Jobbnorge kundeservice - de hjelper deg gjerne.
Vi gjør oppmerksom på at informasjon om søkerne kan bli offentliggjort i henhold til offentlighetsloven, selv om du har bedt om unntak fra søkerlisten. Du vil bli informert dersom unntaket ikke kan tas til følge før opplysningene eventuelt blir offentliggjort.
Mangfold og positiv særbehandling
INN mener at inkludering og mangfold er en styrke. Vi ønsker medarbeidere med ulike kompetanser, fagkombinasjoner, livserfaringer og perspektiver for å bidra til enda bedre oppgaveløsning. Vi vil tilrettelegge for medarbeidere som har behov for det. Aktuell tilrettelegging kan for eksempel være tekniske hjelpemidler, tilpasning av møbler eller endring av rutiner, arbeidsoppgaver og arbeidstid.
Dersom det er kvalifiserte søkere med funksjonsnedsettelse, hull i CV-en eller innvandrerbakgrunn, skal vi innkalle minst én søker i hver av disse gruppene til intervju. For å bli vurdert som søker i disse gruppene, det vil si positivt særbehandlet på denne måten, må søkerne oppfylle visse krav. Du kan lese mer på arbeidsgiverportalen.
Vi oppfordrer deg til å krysse av i jobbsøkerportalen dersom du har funksjonsnedsettelse, hull i CV-en eller innvandrerbakgrunn. Avkrysningene i jobbsøkerportalen danner grunnlag for anonymisert statistikk som alle statlige virksomheter rapporterer i sine årsrapporter.
FerdigheterAI-generert
- Bioingeniørfaglig kompetanse
- Bioteknologi
- Higher Education and Research (IS-HER)
- Kunnskap om landbruksnæringen
- Skogbrukledelse
- Utdanningsadministrasjon
JobbMatch
BetaEr du kvalifisert for jobben?
Nysgjerrig på om du kvalifiserer til denne jobben? Med JobbMatch får du umiddelbar tilbakemelding på hvor godt din profil matcher stillingsutlysningen.
Om arbeidsgiveren
Universitetet i Innlandet har om lag 15 000 studenter og 1 400 ansatte. Vi har studiesteder i Lillehammer, Hamar, Elverum, Rena, Evenstad og på Blæstad, og tilbyr også noen utdanninger på Kongsvinger, Tynset og i Oslo.
NOKUTs styre godkjente Høgskolen i Innlandets søknad om universitetsakkreditering den 12. september 2024. 8. november besluttet kongen i statsråd at høgskolen ble Norges 11. universitet.
Universitetet i Innlandet er kjent for sterke og solide utdannings- og forskningsmiljøer som setter spor etter seg regionalt, nasjonalt og internasjonalt.
Visjonen vår er «Sterkere sammen - vi bygger universitetet i tverrfaglig fellesskap, sammen med samfunns- og arbeidsliv.»
- Sektor: Offentlig
- Sted: Holsetgata 31, 2318 Hamar
- Bransje: Forskning, utdanning og vitenskap
- Stillingsfunksjon: Ledelse, Professor/Førsteamanuensis
Nøkkelord
dekan, økologi, landbruksfag, ledererfaring, bioteknologi
Halvor Mykleby / Universitetet i Innlandet (1/7)
Annonseinformasjon
- FINN-kode 450947157
- Sist endret